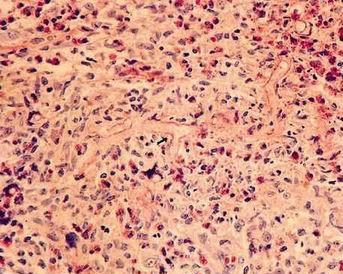
毛霉病(mucormycosis)是一种较少见而往往又是致命的条件性真菌感染

mucormycosis

一种叫毛霉菌(mucormycosis)的感染病正在印度快速蔓延.
图片尺寸640x360
cadm1是早期蕈样肉芽肿的诊断标志物:58例多中心研究
图片尺寸1080x954
毛霉菌性肉芽肿mucormycosisgranuloma的症状表现
图片尺寸888x665
pulmonarymucormycosis
图片尺寸1596x1196
蕈样肉芽肿(mycosis fungoides)(mf)27
图片尺寸350x322
治疗毛霉病的药物三剑客一文厘清用药规范
图片尺寸561x383
医学 真菌性皮病ppt 共分享 真菌病的分类 classification of mycosis
图片尺寸1080x810
path mini-2
图片尺寸500x375
and severe covid-19 converge:the perfect storm for mucormycosis
图片尺寸928x649
着色霉菌病(chromomycosis)着色霉菌病(chromomycosis) 着色霉菌病
图片尺寸560x397
相关问题致命切割 里面浑身是包的女人得了什么病蕈样真菌病(mycosis
图片尺寸270x385
蕈样真菌病(mycosis fungoides,mf)是一种t细胞起源的恶性肿瘤(图1).
图片尺寸469x653
pulmonarymucormycosis
图片尺寸500x336
高渗性高血糖状态的诊断与鉴别依据
图片尺寸900x308
细胞子刊科学家破解真菌破坏血脑屏障诱发阿尔茨海默病相关病理的机制
图片尺寸831x231
broad, non-septate hyphae seen here are characteristic for mucor
图片尺寸504x331
recent advances in the understanding and management of mucormy
图片尺寸1000x636
毛霉病(mucormycosis)是一种较少见而往往又是致命的条件性真菌感染
图片尺寸343x274
毛霉菌(mucormycosis/black fungus)通常存在于土壤,空气,植物,腐烂的
图片尺寸964x480
罕见淋巴瘤新药ccr4靶向药poteligeo莫格利珠单抗3期
图片尺寸540x260